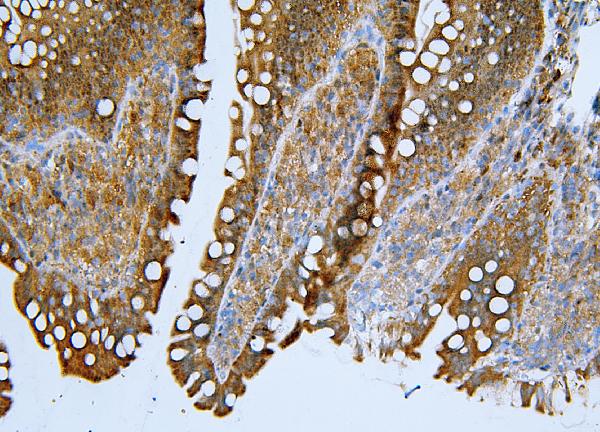
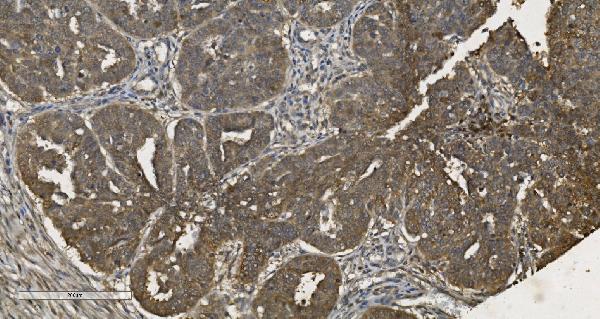

Filters
Clonality
Type
Reactivity
Gene Name
Isotype
Host
Application
Clone
7106 results for " Mouse" - showing 6950-7000
TJP2/ZO2, Polyclonal Antibody (Cat# AAA19265)
HP1 alpha/CBX5, Polyclonal Antibody (Cat# AAA19266)
Clathrin heavy chain/CLTC, Polyclonal Antibody (Cat# AAA19270)
ApoER2/LRP8, Polyclonal Antibody (Cat# AAA19275)
DYNLL1/PIN, Polyclonal Antibody (Cat# AAA19276)
Arp2/ACTR2, Polyclonal Antibody (Cat# AAA19284)
TAGLN/Transgelin, Polyclonal Antibody (Cat# AAA19286)
HNRNPH3, Polyclonal Antibody (Cat# AAA19338)
SEC14L3/TAP2, Polyclonal Antibody (Cat# AAA19342)
MPI, Monoclonal Antibody (Cat# AAA19349)
TIMM8A/DDP, Polyclonal Antibody (Cat# AAA19317)
MCM5, Monoclonal Antibody (Cat# AAA19377)
eRF1/ETF1, Monoclonal Antibody (Cat# AAA19383)
Ran, Polyclonal Antibody (Cat# AAA19131)
No cross reactivity with other proteins.
FOXO4, Polyclonal Antibody (Cat# AAA31400)
Predicted Reactivity: Bovine (91%), Horse (83%), Sheep (91%), Dog (91%)
RAD17, Polyclonal Antibody (Cat# AAA31431)
Predicted Reactivity: Pig (100%), Bovine (100%), Horse (100%), Sheep (100%)
AIRE, Polyclonal Antibody (Cat# AAA31324)
YB1, Polyclonal Antibody (Cat# AAA31294)
GSK3 beta, Polyclonal Antibody (Cat# AAA31297)
Bub1, Polyclonal Antibody (Cat# AAA31312)
ARRB1, Polyclonal Antibody (Cat# AAA31314)
HSP70, Monoclonal Antibody (Cat# AAA27747)
CD31, Monoclonal Antibody (Cat# AAA12258)
Gr-1, Monoclonal Antibody (Cat# AAA12257)
Transketolase/TKT, Polyclonal Antibody (Cat# AAA19254)
YTHDF2, Polyclonal Antibody (Cat# AAA19260)
RCC1, Polyclonal Antibody (Cat# AAA19263)
OTULIN, Polyclonal Antibody (Cat# AAA19319)
DNAJC10, Polyclonal Antibody (Cat# AAA19320)
PDIA5, Polyclonal Antibody (Cat# AAA19331)
MCM6, Monoclonal Antibody (Cat# AAA19372)
U2AF65/U2AF2, Monoclonal Antibody (Cat# AAA19375)
CHCHD10, Polyclonal Antibody (Cat# AAA19310)
VPRBP/DCAF1, Polyclonal Antibody (Cat# AAA19343)
MCM2, Monoclonal Antibody (Cat# AAA19351)
EEF2/Elongation factor 2, Polyclonal Antibody (Cat# AAA19229)
MEK2/MAP2K2, Polyclonal Antibody (Cat# AAA19230)
REA/PHB2, Polyclonal Antibody (Cat# AAA19273)
PSMB5/MB1, Polyclonal Antibody (Cat# AAA19274)
PDIA6, Polyclonal Antibody (Cat# AAA19282)
LRRK2, Polyclonal Antibody (Cat# AAA31287)
Ret, Polyclonal Antibody (Cat# AAA31389)
Predicted Reactivity: Pig (100%), Bovine (100%), Sheep (100%), Rabbit (100%), Dog (100%)
INCENP, Polyclonal Antibody (Cat# AAA31457)
Predicted Reactivity: Pig (100%), Zebrafish (100%), Horse (100%), Sheep (89%), Rabbit (100%), Dog (100%), Chicken (100%)